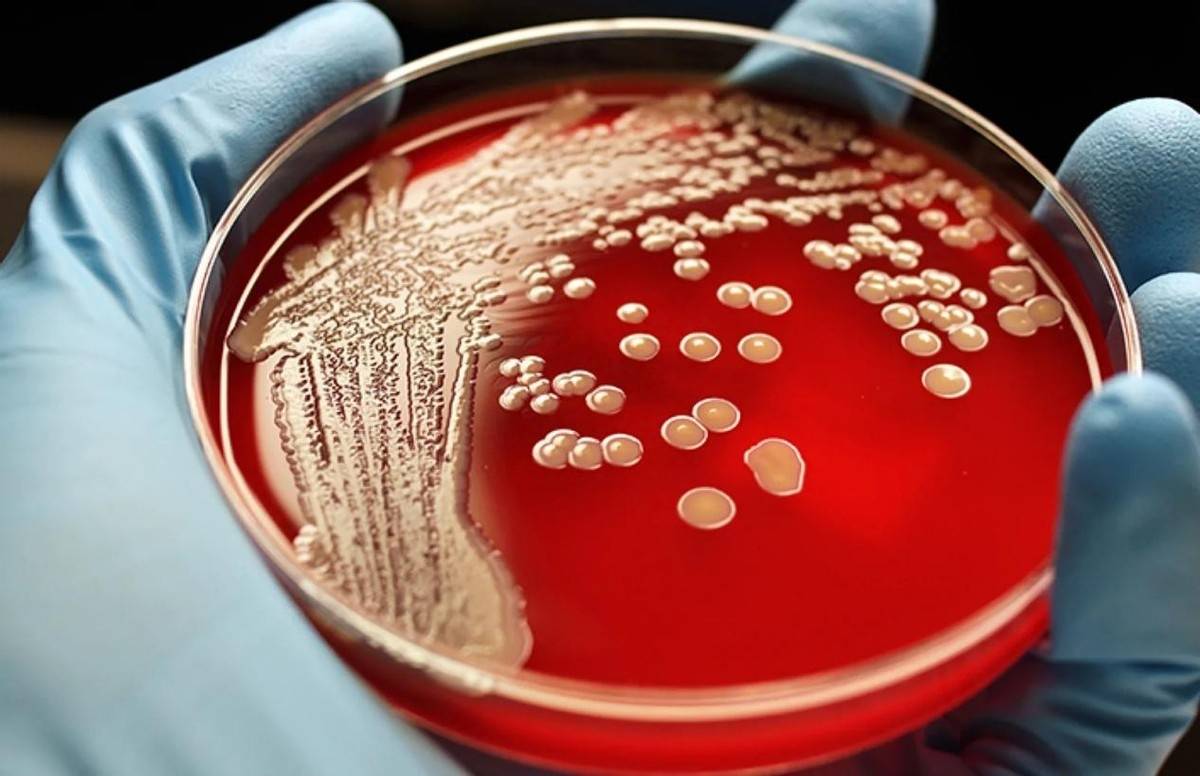

While you may not get any free spins with Ignition Casino, you will enjoy rewards with every reel spin and one of the biggest slots bonuses we've seen.
While you can try your hand at the real money slot games, Slots Empire also offers free slots for practicing.
It's a great size and looks just as good as it did when he opened it!" -Amanda M.
A pair of comfy slippers you can wear to help you fall asleep in when it's dark.
florida sports betting updateFlorrior ,
I never would and I pray you never will either.
揭示生命的多样性
生命科学领域长期关注着生命的起源、进化和多样性。随着技术的不断发展,我们探索到了许多基本单位的微观世界,如细胞、核酸和蛋白质等。然而,在不同地理环境中隐藏着不为人知的奇特生命形态,其中有些可能具有巨大的体积和复杂的结构。

该项研究通过采集多个深海样本中的微生物,利用高通量DNA测序技术对其进行分析。其中发现了一种体积明显超过常见细菌的巨大细胞。进一步的研究揭示,这种细菌不仅大小惊人,形态上也与其他细菌存在很大差异。
据相关科学家介绍,这种细菌的体积相当于普通细菌的数百倍,且拥有复杂的细胞内器官,可能在漫长的进化过程中适应了极端环境。
这一伟大发现不仅令人震惊,更重要的是它拓宽了我们对生命的认知。以往关于细菌的研究主要集中在常见的、相对小型的细菌上,而史上最大细菌的曝光为我们展示了生命的多样性和无穷的可能性。
这一发现不仅对基础学科有着重要意义,还具有潜在的应用价值。对巨大细菌的进一步研究或许有助于解开生命演化的奥秘,为医学、环境保护和工业生产等领域提供新的启示。
这一伟大发现将极大地改变我们对生命系统的认识和理解。科学家们可以继续深入研究这种巨大细菌,以了解其进化机制、代谢途径等重要信息,从而更好地揭示生物多样性的起源和进化历程。此外,从巨大细菌身上获得的有关细胞内器官的知识,也有望为细胞生物学领域的研究提供新的指导。
![]()
通过揭示史上最大细菌的存在,科学家们带给了我们全新的关于生命多样性的认识。这一重要发现不仅展示了生命的惊人能力和适应性,也为我们更深入地了解生命的起源和多样性提供了新的线索。相信随着科技的发展和研究的深入,我们将会揭示更多神秘的生物形态,为人类带来更广阔的科学前景。
对生态环境产生重大影响
细菌的面积与形态:这个被称为“巨型细菌”的生物被科学家们归类为一种梭状细菌。其长度超过了一毫米,是常见细菌的数百倍。此外,据报道,这个巨型细菌还拥有非常特殊的形态,具有分枝伸展的纤维状外观。
细菌的发现:这个巨型细菌最初是在深海热液喷口附近的一个海底火山口发现的。科学家怀疑这种细菌是由于环境异常的高温、高压以及丰富的化学物质而得以生存和繁衍。
细菌的影响:生态平衡的改变:巨型细菌的出现可能对生态系统的平衡产生重大影响。这些细菌的存在可能改变了生态系统的食物链结构。如果巨型细菌开始繁殖并占据生态位,它们可能与其他生物竞争食物资源,进而破坏整个生态系统的稳定性。
![]()
营养循环的改变:细菌在自然界中起着重要的营养循环作用,例如分解有机物质、氮循环等。然而,巨型细菌的特殊形态和生理特性可能导致其独特的营养循环方式,这可能会扰乱现有的生物地球化学循环模式。
生物多样性减少:巨型细菌对其他微生物的竞争能力可能很强,这可能导致其他微生物的数量减少,从而造成生物多样性的丧失。生物多样性的降低将会威胁到整个生态系统的稳定性和健康。
应对措施: 监测与研究:科学家们需要对巨型细菌进行深入研究,以了解其生态学和生理学特征。同时,建立监测机制,以及研发相应的防控措施,以应对潜在的生态影响。
提高环境意识:公众对于环境保护和生态平衡的意识需要不断提高。通过教育和宣传,引导人们正确对待和处理细菌带来的可能的生态问题。
为抗生素研发提供新线索
这种巨型细菌,科学家们将其命名为“Titanospirillum velox”。它是一种拥有壮丽外形的细菌,其长度可达到几毫米,是已知细菌中体型最大的一种。
![]()
不仅如此,它的细胞壁也格外厚实,富含一种罕见的高分子聚合物,这使得它能够生存于极端环境和极端温度条件下。通过对这种巨型细菌的研究,科学家们发现了一些关键的特点,这些特点或许可以帮助人类更好地理解和开发抗生素。
这种巨型细菌具有极强的抗生素抵抗能力。在实验室中,科学家们发现常见的抗生素对它几乎没有任何影响。这一发现引发了科学家们的猜想:或许这种细菌的细胞壁中的高分子聚合物具有抗生素抵抗的特性。如果科学家们能够深入研究这种聚合物的构造和功能,或许可以为抗生素研发提供新的思路和方向。
这种巨型细菌具有极强的自我修复能力。科学家们发现,即使将这些细菌置于极端的环境条件下,例如高温、高压或者强酸强碱等,它们的细胞壁仍然能够迅速修复,并保持生命活性。
这一特性使得科学家们开始思考:或许可以通过研究这种细菌的细胞修复机制,开发出一种全新的抗生素,能够在细胞水平上实现自我修复的效果,从而提高治疗效果和降低副作用。
![]()
这种巨型细菌还具有极快的繁殖速度和适应能力。科学家们的实验表明,它们能够在极端的环境中迅速繁殖,适应各种生存条件。这一特性使得科学家们开始思考:或许可以通过研究这种细菌的繁殖和适应机制,了解其对抗生素产生耐药性的原理,并从中寻找对策,以避免细菌耐药性的发展。
无论真实性如何,这个故事也提醒我们在科学探索中的无限可能性。我们常常只关注已知的事物,而忽视了隐藏在未知领域中的惊喜和谜题。这个超长细菌的发现,或许只是科学进步中的冰山一角,充满更多不可思议的未解之谜等待着我们发现。
校稿:北海
审核:糖糖